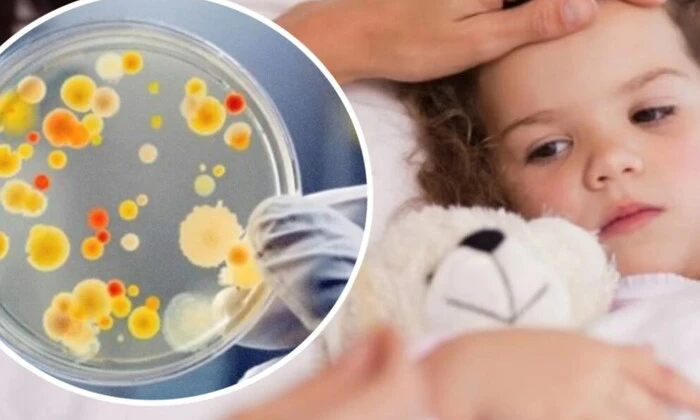
Отравление учеников и учителя в лицее

Во Львове массовое отравление в школе: 10 пострадавших, среди них 9 детей

Как сообщает glavcom.ua: Во Львове десять человек, среди них девять детей и учительница, были госпитализированы с симптомами острого кишечного воспаления после еды в школьной столовой. Тошнота, рвота, боль в животе и диарея - вот что они испытали после столовой. Пациенты были госпитализированы в Львовскую областную инфекционную больницу, где сейчас получают лечение.
«Дети начали поступать 5 ноября, в этот день были госпитализированы двое учеников, 6 ноября - пятеро и 7 ноября - еще трое. Сейчас на лечении в больнице находятся 9 школьников и учительница», - сообщил медицинский директор больницы Андрей Орфин.
Медицинский директор больницы подтвердил, что состояние больных оценивается как средней тяжести, а причина отравления пока неизвестна. Специалисты проводят расследование, опрашивают больных, изучают продукты, которые они употребляли, и взаимодействуют с работниками заведения для установления причин отравления.
Вспышки острых кишечных инфекций в различных регионах:
В Министерстве здравоохранения зафиксировано три вспышки острых кишечных инфекций в других областях, в которых заболели 70 человек, из них 19 детей. Также в Днепровском районе Киева зафиксировано четыре случая острого кишечного воспаления среди детей из дошкольного заведения, которые также проходят лечение и обследование для определения источника инфекции.
Сообщение об отравлении во Львове стало лишь частью более широкого всплеска инфекций в различных регионах Украины, который пока остается под тщательным контролем медицинских служб. Медики уже проводят тщательное расследование, чтобы установить причины этих инцидентов и предотвратить подобные случаи в будущем.
Читайте также













